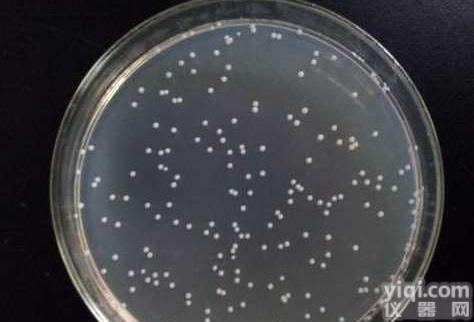
小鼠<em>前列腺</em><em>平滑肌</em>细胞

食蟹猴前列腺平滑肌细胞,Cynomolgus Monkey Prostate Smooth Muscle Cells
- 品牌:Cell Biologics
- 型号:MK-6041
- 产地:美国
- 供应商:妙通(上海)生物科技有限公司
- 供应商报价:¥12780
- 标签:食蟹猴前列腺平滑肌细胞,Cynomolgus Monkey Prostate Smooth Muscle Cells、食蟹猴前列腺平滑肌细胞,Cynomolgus Monkey Prostate Smooth Muscle Cells价格、食蟹猴前列腺平滑肌细胞,Cynomolgus Monkey Prostate Smooth Muscle Cells厂家、、Cell Biologics、妙通(上海)生物科技有限公司